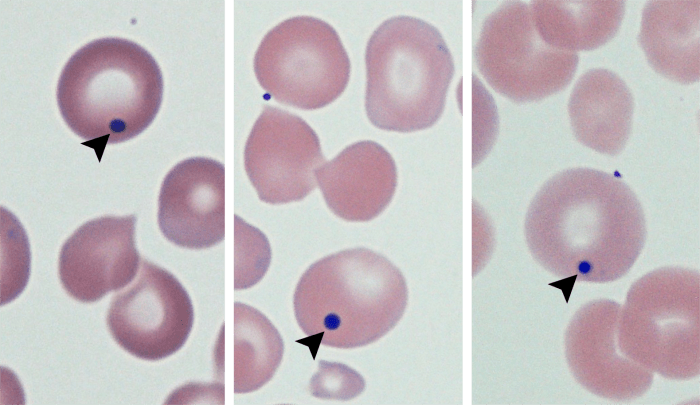
Howell-Jolly Bodies 3-5 (Canine 2-4) ARROWS

Howell-Jolly Bodies
Morphology: small, round, dark purple inclusions within red blood cells. Usually only 1 per red cell. Howell-Jolly bodies are nuclear remnants (small fragments of non-functional nucleus that were not expelled when the red blood cell was released from the bone marrow).
Look alike: parasitemia (ie. Anaplasma marginale, Mycoplasma sp.)
Clinical relevance: normal in healthy cats and healthy horses. Presence of Howell-Jolly bodies in dogs and cattle, or excessive numbers in cats and horses, can be associated with: regenerative anemia, impaired splenic function (ie. splenectomy, corticosteroids), and erythroid dysplasias.


